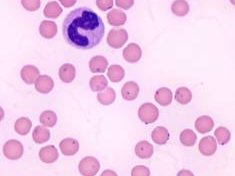
마이코플라즈마 폐렴 해결방법

현재 중국발 폐렴이 유행하고 있다. 마이코플라즈마 다. 마이코플라스마이기도 하다 그래서 의약품관련주가 상승할것으로 보인다.
마이코플라즈마 폐렴
최근 중국에서 유행하고 있는 폐렴이다. 정부에서는 어떻게 변화하는지 주의 하고 있다. 대만에서는 현재 비상이 걸렸다. 우리나라도 안심할수가 없다. 언제든지 코로나처럼 될수 있는 것이다.특히 어린이에게 치명타다.
어린아이 환자가 늘어나고 있다. 한의원은 어린환자로 북새통이다. 어른 보다 아이에게 위험하다. 자녀가 있다면 주의 하도록 하자.
마이코플라즈마 해결방법
마이코플라즈마 해결방법은 마스크를 착용하는것이다. 호흡기 질환은 마스크를 착용하는 것이 좋다. 그리고 상황이 나아질때까지 외출을 하지 않는 것이다. 코로나에 다들 익숙하다. 외출을 하지 않아도 모든 것이 배달이 된다. 외출하고 오면 손부터 씻는다. 손을 씻는 것 만으로도 많은 세균이 떨어진다.
마이코플라스마 관련주
마이코플라스마 관련주는 당연히 항생제이다. 중국에서는 항생제를 사려고 난리다. 사재기 하는 현상도 있다.
국제약품
1959년에 설립되었다. 케이제이커어를 보유한다. 그리고 관련회사 6개를 동시에 가지고 있다. 항생제 관련주다. 국제약품은 인정되는 회사다.의약품 판매 제조 회사다 다양한 항생제를 판매한다. 그리고 황사 마스크도 판매한다. 중국폐렴의 영향으로 우선 마스크 판매가 올라갈 것이라 생각한다. 관심을 가지고 보자
광동제약
영업은 약국 영업과 병원 영업이다.우리에게 친숙한 기업이다. 제주 삼다수와 비타 500이다. 중국폐렴의 영향으로 의약품에 관심을 가지게 된다. 그래서 물과 비타민 음료를 찾게 된다. 중국폐렴의 영향으로 이회사의 주요품목이 증가하게 된다.약국 영업으로 청심원류가 잘나간다. 중국폐렴이 유행한다. 당연히 이기업 매출은 올라간다.